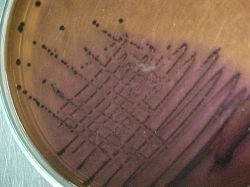
Disminuyeron los coliformes fecales en costas de capital

Disminuyeron los coliformes fecales en costas de capital
La alta salinidad de las aguas disminuyó la presencia de coliformes fecales en las playas de Montevideo durante la última temporada veraniega.
Así lo concluye un estudio de evaluación de la calidad del agua de las playas y costa realizados por el Laboratorio de Calidad Ambiental de la Intendencia, que compara las dos últimas temporadas.
En la temporada 2010 - 2011 el ingreso de masas de agua provenientes del océano Atlántico condujo a mayores salinidades y un aumento de la penetración de los rayos solares, ambos factores con importante efecto bacte.
Foto: microinmuno.qb.fcen.uba.arricida.